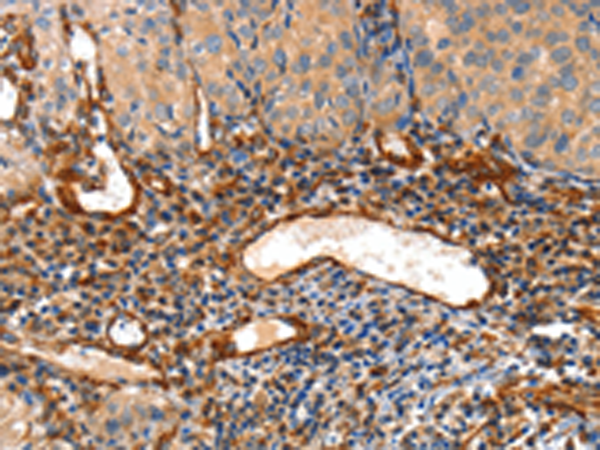

中文名稱:兔抗AIFM3多克隆抗體
英文名稱: Anti-AIFM3 rabbit polyclonal antibody
別 名: AIFL
相關(guān)類別: 一抗
抗 原: AIFM3
儲(chǔ) 存: 冷凍(-20℃)
宿 主: Rabbit
反應(yīng)種屬: Human, Mouse
標(biāo) 記 物: Unconjugate
技術(shù)規(guī)格
|
Background: |
AIFL (apoptosis-inducing factor-like), also known as AIFM3 (apoptosis-inducing factor, mitochondrion-associated, 3), is a 605 amino acid protein that localizes to the mitochondrion and contains one rieske domain. Expressed ubiquitously in tissues including liver, thymus, ovary, bone marrow and cerebral cortex, AIFL functions to induce apoptosis, specifically through a caspase-dependent pathway, and may also play a role in the modulation of mitochondrial membrane potential. Multiple isoforms of AIFL exist due to alternative splicing events. The gene encoding AIFL maps to human chromosome 22, which houses over 500 genes and is the second smallest human chromosome. |
|
Applications: |
ELISA, WB, IHC |
|
Name of antibody: |
AIFM3 |
|
Immunogen: |
Fusion protein of human AIFM3 |
|
Full name: |
apoptosis-inducing factor, mitochondrion-associated, 3 |
|
Synonyms: |
AIFL |
|
SwissProt: |
Q96NN9 |
|
ELISA Recommended dilution: |
1000-5000 |
|
IHC positive control: |
Human cervical cancer and human thyroid cancer |
|
IHC Recommend dilution: |
50-200 |
|
WB Predicted band size: |
67 kDa |
|
WB Positive control: |
Hela cells |
|
WB Recommended dilution: |
200-1000 |

購物車
購物車 幫助
幫助
 021-54845833/15800441009
021-54845833/15800441009
